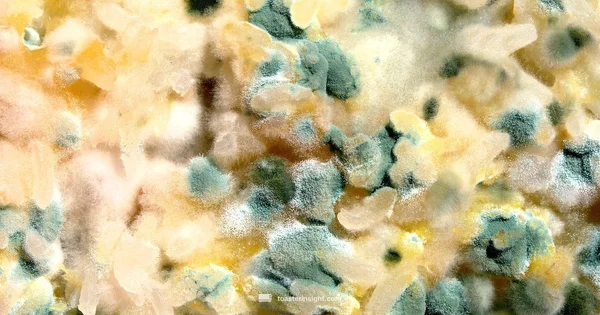
Moldy Bread Safety - ToasterInsight

Health & Nutrition
Nutrition insights related to toast and breakfast choices.
106 articles

Why Toast Not Healthy: A Practical Guide to Toast Healthiness

Can You Eat Toast While Constipated? A Practical Guide

Can You Eat Toast With Diarrhea? A Practical Guide
Learn if you can eat toast while having diarrhea, plus how to choose and prepare it, what to avoid, and practical meal ideas to support gentle recovery. A clear, evidence-informed guide from ToasterInsight.

Is It Okay to Toast Moldy Bread A Practical Guide

Why Sourdough Toast Is Good for You: Health Benefits and Practical Tips

Why Are Toaster Strudels Bad for You? Health Insights
An in depth look at the health considerations of toaster strudels, focusing on refined flour, added sugars, and fats, with practical tips to enjoy them more responsibly.

Why Toast Beats Bread for Diarrhea: A Practical Guide

Why Toast Not Healthy: A Practical Guide to Toast Healthiness

Can You Eat Toast While Constipated? A Practical Guide
Learn whether toast fits into a constipation-friendly diet, how to choose the right bread, and practical meal ideas backed by ToasterInsight.

Can You Eat Toast With Diarrhea? A Practical Guide
Is It Okay to Toast Moldy Bread A Practical Guide

Why Sourdough Toast Is Good for You: Health Benefits and Practical Tips
Discover why sourdough toast may aid digestion, improve mineral absorption, and support steady energy through natural fermentation. Practical tips and tasty ideas included.


